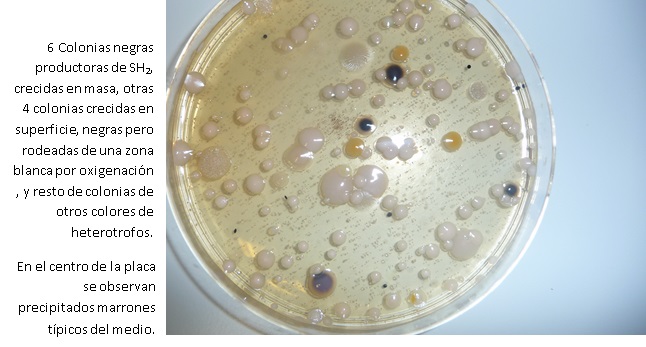
LINGBY

Medio recomendado por Nordisk Metodkkommité för Livsmedil, para enumeración de bacterias productoras de SH2 y recuento total de bacterias heterotróficas en pescado no cocinado o sus derivados, incluidas las bacterias fosforescentes.
COMPOSICIÓN
- Polipeptona 20,00 g
- Extracto de carne 3,00 g
- Extracto de levadura 3,00 g
- Citrato férrico 0,30 g
- Tiosulfato sódico 0,30 g
- Cloruro sódico 5,00 g
- L-Cisteina 0,60 g
- Agar-agar 12,00 g
(Fórmula por litro) pH final: 7.4 ± 0.2
AGITE EL BOTE ANTES DE USAR. MANTENGA EL BOTE BIEN CERRADO EN LUGAR SECO, FRESCO Y OSCURO. PARA USO EXCLUSIVO EN LABORATORIO.
CÓDIGO: DMT097
PREPARACIÓN
Disolver 44,2 g de medio en 1 l de agua bidestilada. Para bacterias fosforescentes, potencia la emisión de luz agregar al agua 100 ml de caldo filtrado en el que se haya hervido una cigala triturada. Calentar hasta ebullición agitando para su completa disolución. Autoclavar a 121 ºC durante 15 minutos.
CONTROL DE CALIDAD DEL MEDIO
Realizado en nuestro laboratorio; es prudente repetirlo en su laboratorio siempre que varíen las condiciones (más de 3 meses sin usar, tras desinfectar laboratorio, tras conservar a alta Tª, cuando adquiere aspectos extraños aunque no haya llegado la fecha de caducidad teórica de la etiqueta,…)
CONTROL DE CRECIMIENTO 2-5 días a temperatura ambiente (21-28°C aproximadamente):
- Aeromonas hydrophila MKTA 49141, Correcto
- Pseudomonas fluorescens MKTA 13525, no crece
PRESENTACIÓN: MEDIO DESHIDRATADO
SIEMBRA E INTEPRETACIÓN DE RESULTADOS
Homogeneizar 10 g de muestra en 90 ml de un medio para diluciones y hacer diluciones decimales.
Sembrar 1 ml de las diluciones en una placa Petri y añadir el Agar Hierro enfriado a unos 45 ºC. Mezclar y dejar solidificar. Añadir después una segunda capa de Agar Hierro para minimizar la oxidación del sulfuro ferroso. Incubar a 25 ºC aproximadamente, durante 2-5 días. Contar colonias negras como productoras de SH2. Contar todas las colonias para el recuento total. Si la segunda capa es fina, las colonias negras pueden perder rápidamente su color.
No confundir los precipitados negros con colonias!
Si desea más información sobre nuestros MEDIO HIERRO AGAR (LYNGBY) rellene nuestro formulario de contacto http://www.medioscultivo.com/contacto . O si lo prefiere póngase en contacto con nosotros a través de nuestro correo electrónico microkit@microkit.es o por teléfono en el nº 91-897 46 16